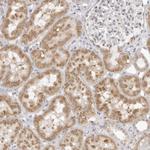
FDPS Antibody in Immunohistochemistry (Paraffin) (IHC (P))

Search
Invitrogen
FDPS Polyclonal Antibody
{{$productOrderCtrl.translations['antibody.pdp.commerceCard.promotion.promotions']}}
{{$productOrderCtrl.translations['antibody.pdp.commerceCard.promotion.viewpromo']}}
{{$productOrderCtrl.translations['antibody.pdp.commerceCard.promotion.promocode']}}: {{promo.promoCode}} {{promo.promoTitle}} {{promo.promoDescription}}. {{$productOrderCtrl.translations['antibody.pdp.commerceCard.promotion.learnmore']}}
产品信息
PA5-55794
种属反应
宿主/亚型
分类
类型
抗原
偶联物
形式
浓度
规格
纯化类型
保存液
内含物
保存条件
运输条件
RRID
产品详细信息
Immunogen sequence: SLVHGYPVLA WHSARCWCQA WTEEPRALCS SLRMNGDQNS DVYAQEKQDF VQHFSQIVRV LTEDEMGHPE IGDAIARLKE VLEYNAIGGK YN
Highest antigen sequence identity to the following orthologs: Mouse - 78%, Rat - 76%.
靶标信息
The isoprene biosynthetic pathway supply the cell with cholesterol, ubiquinone, and various nonsterol metabolites. The farnesylpyrophosphate synthetase enzyme catalyzes the formation of geranyl and farnesylpyrophosphate from isopentenylpyrophosphate and dimethylallyl pyrophosphate. Analysis of FDPS activity and protein in rat liver, accompanied by immunofluorescence and immunoelectron microscopy studies, demonstrated that FDPS is predominantly localized in peroxisomes. 1 Liver tissue from patients with the peroxisomal deficiency diseases Zellweger syndrome and neonatal adrenoleukodystrophy exhibit diminished activities of FDPS and subsequent isoprenoid synthesis.
仅用于科研。不用于诊断过程。未经明确授权不得转售。
篇参考文献 (0)
生物信息学
蛋白别名: (2E,6E)-farnesyl diphosphate synthase; Dimethylallyltranstransferase; Farnesyl diphosphate synthase; Farnesyl pyrophosphate synthase; farnesyl pyrophosphate synthetase; farnesyl pyrophosphate synthetase (EC 2.5.1.1); farnesyl pyrophosphate synthetase, dimethylallyltranstransferase, geranyltranstransferase; FPP synthase; FPP synthetase; Geranyltranstransferase; KIAA1293; unnamed protein product
基因别名: FDPS; FPPS; FPS; KIAA1293; POROK9
UniProt ID: (Human) P14324
Entrez Gene ID: (Human) 2224